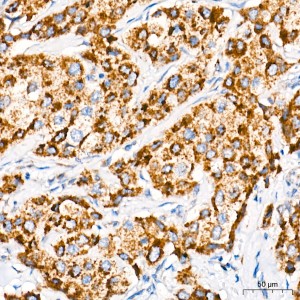
KD-Validated CHCHD4 Rabbit mAb (20 μl)

Your shopping cart is empty!
KD-Validated CHCHD4 Rabbit mAb (20 μl)
| Reactivity: | Human, Mouse Rat |
| Applications: | WB, IHC, IF/IC, ELISA |
| Host Species: | Rabbit |
| Isotype: | IgG |
| Clonality: | Monoclonal antibody |
| Gene Name: | coiled-coil-helix-coiled-coil-helix domain containing 4 |
| Gene Symbol: | CHCHD4 |
| Synonyms: | MIA40; TIMM40 |
| Gene ID: | 131474 |
| UniProt ID: | Q8N4Q1 |
| Immunogen: | Recombinant fusion protein containing a sequence corresponding to amino acids 1-105 of human CHCHD4 (NP_001091972.1). |
| Purification Method: | Affinity purification |
| Dilution: | WB 1:13000 - 1:78000; IHC 1:600-1:3000; IF/IC 1:50-1:200 |
| Concentration: | 1.32 mg/ml |
| Buffer: | PBS with 0.09% Sodium azide, 0.05% BSA, 50% glycerol, pH7.3. |
| Storage: | Store at -20°C. Avoid freeze / thaw cycles. |
| Documents: | Manual-CHCHD4 monoclonal antibody |
Background
CHCHD4, a component of human mitochondria, belongs to a protein family whose members share 6 highly conserved cysteine residues constituting a -CXC-CX(9)C-CX(9)C- motif in the C terminus (Hofmann et al., 2005 [PubMed 16185709]).
Images
 | Western blot analysis of various lysates using [KD Validated] CHCHD4 Rabbit mAb (A27252) at 1:13000 dilution incubated at room temperature for 1.5 hours. Secondary antibody: HRP-conjugated Goat anti-Rabbit IgG (H+L) (AS014) at 1:10000 dilution. Lysates/proteins: 25 μg per lane. Blocking buffer: 3% nonfat dry milk in TBST. Detection: ECL Basic Kit (RM00020). Exposure time: 10s. |
 | Western blot analysis of lysates from wild type (WT) and CHCHD4 knockdown (KD) 293T cells using [KD Validated] CHCHD4 Rabbit mAb (A27252) at 1:13000 dilution incubated at room temperature for 1.5 hours. Secondary antibody: HRP-conjugated Goat anti-Rabbit IgG (H+L) (AS014) at 1:10000 dilution. Lysates/proteins: 25 μg per lane. Blocking buffer: 3% nonfat dry milk in TBST. Detection: ECL Basic Kit (RM00020). Exposure time: 10s. |
 | Immunohistochemistry analysis of paraffin-embedded Human breast cancer tissue using [KD Validated] CHCHD4 Rabbit mAb (A27252) at a dilution of 1:600 (40x lens). High pressure antigen retrieval performed with 0.01M Tris-EDTA Buffer (pH 9.0) prior to IHC staining. |
 | Immunohistochemistry analysis of paraffin-embedded Human kidney tissue using [KD Validated] CHCHD4 Rabbit mAb (A27252) at a dilution of 1:600 (40x lens). High pressure antigen retrieval performed with 0.01M Tris-EDTA Buffer (pH 9.0) prior to IHC staining. |
 | Immunohistochemistry analysis of paraffin-embedded Human tonsil tissue using [KD Validated] CHCHD4 Rabbit mAb (A27252) at a dilution of 1:600 (40x lens). High pressure antigen retrieval performed with 0.01M Tris-EDTA Buffer (pH 9.0) prior to IHC staining. |
 | Immunohistochemistry analysis of paraffin-embedded Rat spleen tissue using [KD Validated] CHCHD4 Rabbit mAb (A27252) at a dilution of 1:600 (40x lens). High pressure antigen retrieval performed with 0.01M Tris-EDTA Buffer (pH 9.0) prior to IHC staining. |
 | Immunohistochemistry analysis of paraffin-embedded Rat lung tissue using [KD Validated] CHCHD4 Rabbit mAb (A27252) at a dilution of 1:600 (40x lens). High pressure antigen retrieval performed with 0.01M Tris-EDTA Buffer (pH 9.0) prior to IHC staining. |
 | Immunohistochemistry analysis of paraffin-embedded Rat testis tissue using [KD Validated] CHCHD4 Rabbit mAb (A27252) at a dilution of 1:600 (40x lens). High pressure antigen retrieval performed with 0.01M Tris-EDTA Buffer (pH 9.0) prior to IHC staining. |
You may also be interested in: